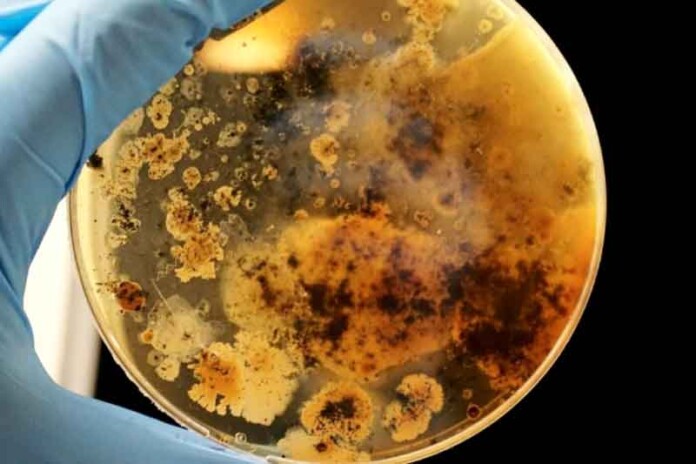

Novo relatório da Organização Mundial da Saúde (OMS) revela que a resistência antimicrobiana está avançando mais rapidamente do que a medicina, com foco especial nas bactérias gram-negativas e uma situação preocupante no Brasil.
A Organização Mundial da Saúde (OMS) emitiu um alerta nesta segunda-feira (13) sobre o avanço preocupante da resistência antimicrobiana (RAM). Segundo o mais recente relatório do Sistema Global de Vigilância da Resistência e do Uso de Antimicrobianos (Glass), uma em cada seis infecções bacterianas registradas no mundo já apresenta resistência a antibióticos.
O estudo, que analisou dados de 104 países entre 2018 e 2023, aponta que mais de 40% das combinações entre patógenos e antibióticos monitoradas tiveram um aumento na resistência, com crescimento médio anual entre 5% e 15%.
“A resistência antimicrobiana está avançando mais rápido que os progressos da medicina moderna, ameaçando a saúde das famílias em todo o mundo”, afirmou o diretor-geral da OMS, Tedros Adhanom Ghebreyesus.
Cenário global e regional
A resistência antimicrobiana é mais grave em regiões com sistemas de saúde frágeis.
- Regiões Mais Afetadas: O Sudeste Asiático e o Mediterrâneo Oriental lideram, com uma média de uma em cada três infecções resistentes.
- África: A proporção é de uma em cada cinco infecções.
As bactérias mais preocupantes
O relatório destaca que as bactérias gram-negativas representam as maiores ameaças, pois são as principais causas de infecções na corrente sanguínea que podem evoluir para sepse, falência de órgãos e morte.
- Tipos Críticos: Escherichia coli ( coli) e Klebsiella pneumoniae.
- Resistência a Tratamento de Primeira Escolha: Mais de 40% das cepas de coli e 55% das de K. pneumoniae são resistentes às cefalosporinas de terceira geração. Na África, essa taxa ultrapassa 70%.
- Opções Reduzidas: Antibióticos essenciais, como carbapenêmicos e fluoroquinolonas, perderam eficácia, forçando o uso de medicamentos de último recurso — que são mais caros e de difícil obtenção.
A situação da resistência no Brasil
No Brasil, o foco de maior preocupação são as infecções da corrente sanguínea.
Principais Patógenos e Resistências:
- Staphylococcus aureus: Responsável por 36,9% dos casos, com 52,8% de resistência à meticilina.
- Klebsiella pneumoniae: Corresponde a 25,5% dos casos, apresentando 41,1% de resistência ao antibiótico imipenem.
- coli: Representa 25,9% dos casos, com 34,6% de resistência às cefalosporinas de terceira geração.
Resistência em Infecções Urinárias (E. coli):
- 46,8% de resistência ao cotrimoxazol.
- 37,5% de resistência às fluoroquinolonas.
- 25,8% de resistência às cefalosporinas.
Reforço na vigilância global
A OMS sublinha a necessidade urgente de fortalecer os sistemas de saúde globais. Embora o número de países participantes do sistema Glass tenha quadruplicado desde 2016 (passando de 25 para 104), quase metade das nações ainda não envia dados.
A Assembleia Geral da ONU aprovou uma declaração política em 2024, estabelecendo metas para aprimorar a vigilância e adotar uma abordagem integrada entre os setores humano, animal e ambiental.
“Nosso futuro depende do uso responsável de antibióticos e do investimento em novos medicamentos, diagnósticos e vacinas”, concluiu Tedros Adhanom Ghebreyesus.











